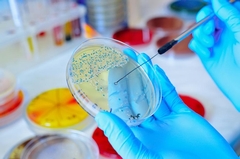
What Temperature Does Mold Die At? Facts Explained

The mere sight of mold in a home can send shivers down any homeowner's spine, triggering questions and concerns about health and property damage. We often hear about the harmful effects of mold, but what temperature does mold die at? Addressing this question is crucial for anyone dealing with mold and looking to access damage restoration services in Eau Claire. Understanding how to effectively manage and eliminate mold can help protect your home and health, while also maintaining the value of your property.
Mold is an unwelcome guest that thrives in environments with moisture and organic materials to feast upon. It's not just unsightly; it also poses significant health risks, particularly for individuals with allergies, asthma, or weakened immune systems. This blog will explore the specifics of mold, its dangers, and effective strategies to eliminate it. From scientific insights into the conditions that kill mold to practical tips for keeping your home mold-free, we've got you covered. Read on to learn how understanding temperature can be a powerful tool in your mold management arsenal.
Understanding Mold: The Basics
Mold is a type of fungus that grows in multicellular structures called hyphae. These hyphae produce spores that can spread easily through the air. Because mold can thrive in damp and humid conditions, it's no surprise that it frequently appears in places like bathrooms, basements, and anywhere there has been water damage. Mold can feed on various materials, including wood, paper, and drywall. Over time, it can weaken these materials, leading to structural damage.
Exposure to mold can lead to health problems, from minor irritations like sneezing and coughing to more severe respiratory issues and allergic reactions. Given these risks, it’s important to manage and remediate mold growth promptly.
Conditions for Mold Growth
Before understanding what temperature does mold die at, it's essential to know the conditions in which it thrives. Mold needs four main things to grow: moisture, warmth, food, and time. Moisture can come from numerous sources, such as leaks, spills, condensation, or poor ventilation. Warmth, generally between 77 and 86 degrees Fahrenheit, is optimal for mold growth. Food sources are abundant in any home - wallpaper, carpet, and insulation can all provide the organic material mold needs.
It usually takes mold 24 to 48 hours to start growing under these conditions. Therefore, any water damage in your home must be addressed quickly to prevent mold from taking hold. The environment in Eau Claire, WI, can sometimes provide favorable conditions for mold, especially during humid summers or in poorly ventilated spaces.
Killing Mold: The Role of Temperature
Now, let’s delve into the heart of the matter - what temperature does mold die at? Extreme temperatures, both hot and cold, can inhibit mold growth. Mold typically dies when exposed to temperatures above 140 degrees Fahrenheit or below freezing. However, merely setting your thermostat to extreme temperatures won't necessarily solve a mold problem, as achieving these temperatures throughout all affected areas can be impractical.
Heat treatments, which can involve professional intervention, can radically raise the temperature to eliminate mold. Conversely, freezing temperatures can halt mold growth but may not kill the spores. Once conditions become favorable again, the spores can become active.
Practical Methods to Control Mold
The Mold Management Checklist
- Inspection and Identification: Start with a thorough inspection to locate the source areas of mold growth. Identify moisture sources that need to be addressed.
- Reduce Moisture Levels: Utilize dehumidifiers in damp areas and fix any leaks in plumbing or roofing. Good ventilation can also help reduce indoor humidity.
- Improve Ventilation: Adequate airflow can limit the humid conditions that mold loves. Use fans in bathrooms and kitchens, and open windows when the weather permits.
- Regular Cleaning and Maintenance: Use mold-resistant products during renovations and clean regularly with mold-killing cleaners in vulnerable areas like bathrooms and kitchens.
- Temperature Control: While adjusting household temperatures alone isn’t sufficient to combat mold, keeping your home well-heated and erring on the side of cooler, drier air can help inhibit mold growth.
Advanced Mold Remediation Techniques
In cases where mold has become widespread, professional intervention may be necessary. Chem Master Restoration provides comprehensive mold removal and remediation in Eau Claire. These services are adept at not only removing mold but also addressing the underlying issues that allowed it to flourish.
Mold removal professionals use a combination of physical cleaning, antimicrobial treatments, and, in some cases, structural repairs to ensure that mold is effectively eradicated. With precise diagnostic tools and an understanding of the local climate, experts can deliver targeted solutions.
The Wider Impact of Mold
Aside from compromising health, mold can decrease property value and lead to expensive repairs. If left unchecked, it can cost homeowners thousands of dollars to fix. When buying or selling a home, mold can become a significant negotiating point - underscoring why proactive measures are vital.
Mold Prevention: A Long-term Strategy
An effective mold management strategy combines immediate action with preventative efforts. Identifying and correcting water intrusion sources, improving ventilation, and maintaining a consistent and moderate indoor climate can help prevent mold from gaining a foothold. It's often easier and less costly to prevent mold than it is to remediate it once it has taken hold.
Effective Mold Solutions with Chem Master Restoration
Living with mold is not only uncomfortable but potentially dangerous. It demands urgent attention, and Eau Claire residents have access to top-tier services from Chem Master Restoration. Whether it's mold removal and remediation or a broader need like water damage repair in Oak Grove, their expertise ensures homes are safe and health-friendly.
For those coping with water damage or mold issues elsewhere, Chem Master Restoration offers solutions tailored to specific needs, whether it's for damage that has already occurred or preventative measures to safeguard your property. Remember, dealing with mold promptly can save money, stress, and health-related issues.
By investing in professional services and maintaining proper home care, you can defend against the challenges posed by mold. Let Chem Master Restoration be your guide to a safer, cleaner living space. Reach out today to tackle these issues head-on and secure your home’s health for the long term.

